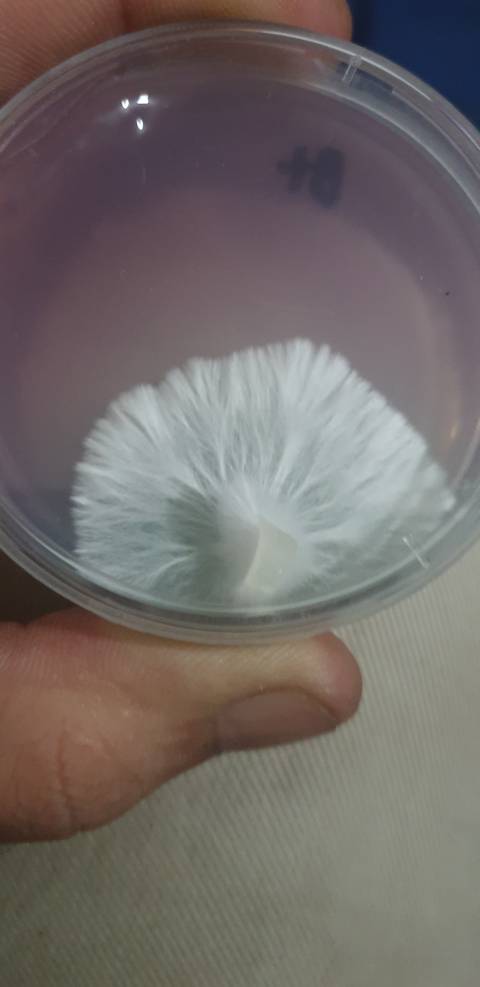
asp3k nude

FREE TRIAL
@asp3k
ASP3K
ASP3K OnlyFans nude asp3k
0photos
~ subscribers
0videos
Earnings are hidden for this model
2likes
Verified & Active
2posts
Popular Profile Last Week
Popular Profile Last Week
Images are property of onlyfans.com/asp3k. We don't
claim any rights.
The OnlyFans account belonging to @asp3k boasts an impressive collection of over 0 videos and 0 photos, a substantial assortment indeed.
Popular Profile Last Week
Similar OnlyFans creators
